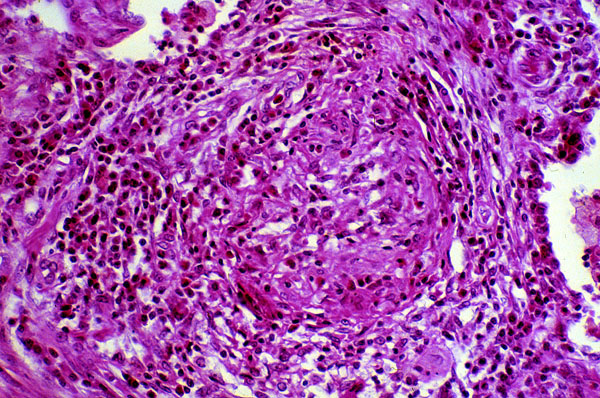

Wegener s granulomatosis, Higher power
Click picture to enlarge. Close window to return
Wegener s granulomatosis. Higher power. There is a predominance of chronic inflammation, with histiocytic proliferation, and a poorly formed non-caseating granuloma. Wegener s granulomatosis is characterized by necrotizing granulomatous inflammation and a necrotizing vasculitis.